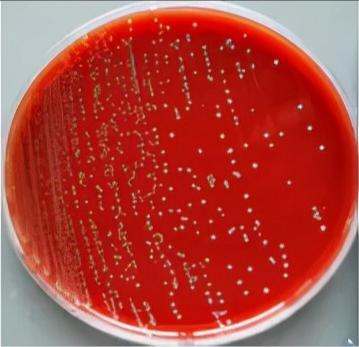

微生物小课堂丨猪猪不准谈“链”爱
 { 冬天,今天也想吃肉肉(╹ڡ╹ )}
{ 冬天,今天也想吃肉肉(╹ڡ╹ )} 步入冬日,肉菜逐渐在饭桌上占有了更多的比例,我们也就更需要重视起食用肉类的预先处理工作。
步入冬日,肉菜逐渐在饭桌上占有了更多的比例,我们也就更需要重视起食用肉类的预先处理工作。处理不好的肉肉很危险!!!

近日,在江门从事厨师工作多年的张先生(化名)在一次切肉工作时不小心割伤了手指。本以为只是小事,然而不久后,他发现自己头痛欲裂,还发起了高烧,就诊时体温高达39.6℃,还出现了烦躁、意识错乱、胡言乱语、小便失禁等情况。经医生诊断,张先生是得了人感染猪链球菌病。

这种疾病是由猪链球菌感染人而引起的人畜共患性疾病,主要通过皮肤的伤口而感染,临床表现为发热、寒战、头痛、食欲下降等一般细菌感染症状,重症患者可合并中毒性休克综合征和链球菌脑膜炎综合征。

个菌资料
猪链球菌属链球菌科,外形上呈球形或卵圆形。这种菌喜欢类生物的生长环境,特别适宜在血培养瓶及血平皿上培养,培养温度为37 ℃、时间18~20小时。该菌在血平板上生长呈细小菌落,无色,半透明,直径0.5~1 mm,边缘整齐,凸起,光滑。
近年,根据细菌荚膜多糖抗原的差异,将猪链球菌分为35个血清型。 虽然猪链球菌的型别众多,但迄今为止,文献报道感染人的猪链球菌只有其中3个型别(1型、2型和14型),尤以2型为常见,也是最常被分离到的猪链球菌型别,其他两个型别仅有个别案报道。

细菌小小 危害不小

猪链球菌不仅是猪的一种常见和重要病原体,也是人类动物源性脑膜炎的常见病因。
它的主要传播途径是经伤口的直接接触感染,带伤洗切病(死)猪肉、冷冻猪肉也可引起发病;因食用未煮熟的病(死)猪肉、内脏,或使用被猪链球菌污染的餐具也会感染。猪链球菌经皮肤或黏膜的伤口进入人体,进入血液循环后在血液中迅速生长和繁殖,即败血症,细菌随血液循环进入人体的各器官、组织,致多器官、组织发生病变。少部分患者发生链球菌中毒性休克综合征,严重病例病情进展非常快,如果诊断、治疗不及时,预后较差,病死率极高!!
猪猪的不自由“链”爱
猪链球菌在猪中有较高的流行性。人感染猪链球菌病的主要源头是感染猪链球菌的病(死)猪,其次是羊、马、鹿、鸟、家禽(如鸭、鸡)等。
然而,猪肉上有猪链球菌不仅是因猪猪生病,还因为猪链球菌本身是一种日常生活中的常见细菌。它可在粪便、灰尘及水中存活较长时间。该菌在60℃水中可存活10分钟,50℃为2小时。在4℃的动物尸体中可存活6周;0℃时灰尘中的细菌可存活1个月,粪中则为3个月;25℃时在灰尘和粪中则只能存活24小时及8天。如果正好又遇上了苍蝇,那就更头疼了,苍蝇能携带猪链球菌2型至少长达5天,污染食物可长达4天。

所以,即便现下严格的市场监管制度能够杜绝绝大多数病死猪流入市场的可能,我们也不能掉以轻心:
猪链球菌不耐高温,在烹调猪肉时一定要彻底煮熟,而长期接触猪或生猪肉的人,也要做好防护,特别是皮肤有伤口时,切勿直接接触生猪肉
处理生熟食品菜板菜刀切记要分开
日常生活中,需通过正规渠道购买检疫合格的肉类
在生猪养殖过程中,饲养人员要多注意个人防护,有外伤时应尽量避免接触病猪,发现病猪要及时通知兽医诊疗
屠宰加工人员在屠宰生猪时需佩戴手套,一旦受伤应立即处理伤口,经清洗消毒后,使用抗菌素预防治疗
总之,猪链球菌病是可防可控的。请务必到正规市场购买猪肉,并确保食用高温煮熟后的健康猪肉。如不慎出现头痛、高热等感染症状,请及时就医。
end
供稿:微生物检验科
继续滑动看下一个轻触阅读原文

普陀疾控向上滑动看下一个
原标题:《微生物小课堂丨猪猪不准谈“链”爱》

